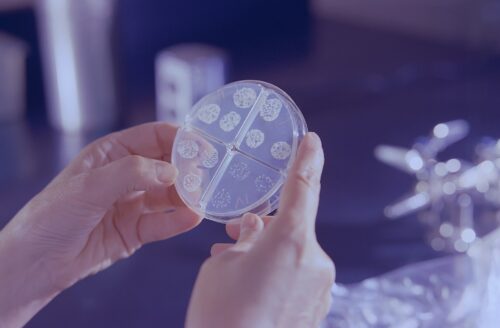

Автор: reform.news
Последние дни на беларусско-польской границе фиксировались единичные случаи попыток нелегального пересечения.
В ночь на 13 сентября в Гродненской области заметили северное сияние. Северное (полярное) сияние происходит
В Беларусь продолжают ввозить компоненты тактического ядерного оружия и сопутствующего оборудования по
В ночь на 13 сентября Россия атаковала юг Одесской области дронами-камикадзе. Повреждена припортовая
Владимир Путин и лидер КНДР Ким Чен Ын встретились на российском космодроме Восточный 13 сентября.
Синоптики объявили желтый уровень опасности на среду, 13 сентября. В западных районах Беларуси ожидается
(обновлено) «Губернатор» Севастополя Михаил Развожаев сообщает о пожаре на южной площадке Севморзавода.
12 сентября беларусский турист погиб при восхождении на Эльбрус, сорвавшись с высоты 5400 метров.
Бомбардировщик Су-24 потерпел крушение в Волгоградской области России 12 сентября. «При выполнении
Авиакомпания «Азербайджанские Авиалинии» (AZAL) открывает рейс Баку — Минск с 1 октября.
Комитет госбезопасности обновил список лиц, причастных к террористической деятельности, и добавил туда
Павел Латушко, представитель по транзиту власти Объединенного переходного кабинета, по согласованию со
МВД Литвы предлагает выдавать паспорта иностранцев не всем беларусам, а только тем, кто пострадал от
В Полоцком районе проходит учебный сбор с военнообязанными территориальных войск. На заключительном этапе
44-летнего гражданина Беларуси приговорили к 3 годам и 9 месяцам тюрьмы в Германии за нападение на польского
Александра Ярошука, главу ликвидированного Беларусского конгресса демократических профсоюзов, переводят
Фельдшеру-лаборанту Хойникского районного центра гигиены и эпидемиологии вместо кала приносили шоколадки
Беларусские военные совершат марш на российский полигон Телемба в Бурятии в рамках второго этапа оперативно-тактического
Артур Михальски назначен специальным представителем МИД Польши по взаимодействию с демократическими силами Беларуси.
В Беларуси заработала система мобильных платежей Huawei Pay. Пока ей воспользоваться могут только держатели
Гражданин Беларуси Сергей Карпушкин, арестованный в США в апреле этого года, пошел на сделку со следствием
Комитет госконтроля выявил приписки занятий по вождению грузовых автомобилей в одном из колледжей Гомельской области.
Силовики задержали студента второго курса Беларусской государственной академии связи. На видео парень
Светлана Тихановская в ходе визита в Швецию встретилась с премьер-министром Швеции Ульфом Кристерссоном
КГБ задержал шесть человек, которые, как утверждается, готовили теракты на железной дороге.
Александр Лукашенко подписал указ, направленный на завершение реализации проектов, финансирование которых
24 августа Россия обстреляла в Черном море гражданское грузовое судно, которое шло под флагом Либерии
В Минск прибыли атташе по вопросам обороны из 14 государств Африки, сообщает Минобороны. Целью визита
Народные посольства Беларуси, Офис Светланы Тихановской и Объединенный переходный кабинет запустили сайт pashpart.
Следственный комитет начал специальное производство в отношении представителей и бывших участников BYPOL
Министерство внутренних дел Литвы предлагает проддлить срок действия паспортов иностранцев в связи с
В Беларуси появилось новое «экстремистское» формирование — телеграм-чат «
11-13 сентября в Полоцком районе в рамках сборов с территориальными войсками пройдет командно-штабное учение.
В 2024 году НАТО проведет крупнейшие со времен холодной войны военные учения. В них примут участие более
За неделю лидские пограничники изъяли три квадрокоптера. 2 сентября по информации от местных жителей
Лидер Северной Кореи Ким Чен Ын посетит Россию с официальным визитом по приглашению Владимира Путина
КГБ заявляет о задержании трех «боевых ячеек», которые якобы работали на СБУ. Среди задержанных
Литва направит в Латвию 20 пограничников для борьбы с нелегальными мигрантами, число которых значительно
Бывшая журналистка из Гомеля Лариса Щирякова не будет обжаловать приговор, сообщает БАЖ. Напомним, Гомельский
Школа в Вильнюсе, где учатся дети беларусов, выдала школьникам дневники с красно-зелеными флагами и словами
Украина вернула под свой контроль «вышки Бойко» — буровые нефте- и газодобывающие платформы
Пробы питьевой воды, отобранной после аварии на водопроводе в Минске, соответствуют нормам, сообщает
Александр Лукашенко ожидает, что Турция подставит плечо Беларуси в «непростой ситуации»
Госпогранкомитет заявляет, что польские пограничники применяют огнестрельное оружие на польско-беларусской границе.
Телеграм-канал «Хрысціянская Візія» признан экстремистскими материалами. Решение принял суд Лидского
Рейтинговое агентство S&P Global Ratings приостановило действие суверенных рейтингов Беларуси.
Александр Лукашенко сегодня проводит встречу с послом Турции Мустафой Озджаном во Дворце Независимости.
Министр иностранных дел Германии Анналена Бербок прибыла в Киев с неанонсированным визитом.
10 сентября незаконно перейти беларусско-латвийскую границу пытались 256 человек. За выходные латвийские
Беларуска Арина Соболенко официально признана первой ракеткой мира. Женская теннисная ассоциация (WTA)